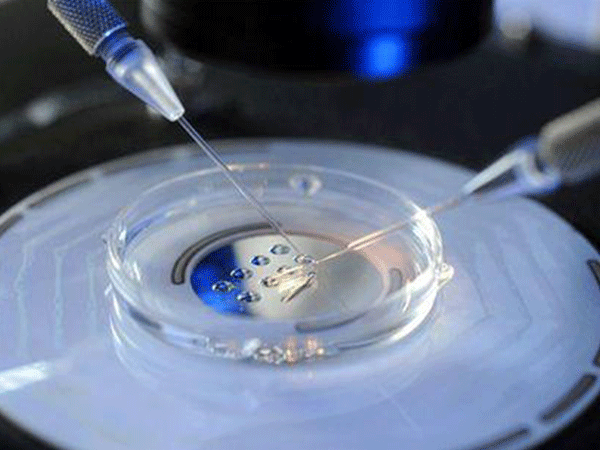
IVF Success Rates for 40+ Women

IVF Success Rates for 40+ Women
INTRODUCTION: When the Fertility Clock Meets the Modern Reproductive Revolution
“Doctor, is there any hope for using IVF at 43?” A late-night consultation with Elena Martínez, a Spanish teacher, speaks to a common anxiety among senior women around the world. And the answer from Dr. Emily Roberts of the Harvard Reproductive Center brings light: “Donor egg in vitro has increased live birth rates for 40+ women by 5x over self-eggs – age is no longer the end of fertility, but the beginning of a new path.” In this article, we will use the 2025 global topical data and real cases to dismantle the success code of age-supported egg donation.
I. International data reveals: the “survival curve” of age and success rate
(I) The Truth about Age Stratification in Global Reproductive Centers
| age groups | Clinical pregnancy rate | live birth rate | Key constraints |
|---|---|---|---|
| 40-42 years | 48%-55% | 38%-42% | Accelerated aging of the uterus |
| 43-45 years | 36%-44% | 25%-32% | 40% decrease in endothelial blood flow |
| ≥46 years old | 22%-30% | 15%-24% | High prevalence of metabolic diseases |
Source: International Federation for Reproductive Medicine Report 2025 (covering 107 centers in 21 countries)
(ii) Cases of “over-age success” that have turned perceptions on their head
American case: Sophia Clark (46 years old), after 3 failed attempts at implantation, was able to increase her endometrial thickness from 6.1mm to 8.9mm through endometrial regeneration therapy (platelet-rich plasma infusion), and eventually gave birth to a healthy baby girl.
Breakthrough in Japan: Yuki Tanaka (48) successfully overcame uterine contraction wave abnormalities and gave birth to twins using a staged embryo transfer (thawing and culturing for 24 hours before transfer).
Dr. James Wilson of Oxford University Fertility Center asserts, “The core value of donor egg in vitro is to reset the ovarian clock – 40 year old women using 25 year old donors have reduced the rate of chromosomal abnormalities in embryos from 80% to 12%”
II. Five Success Variables: Precision Regulation from Laboratory to Uterus
(i) The “gold standard” of egg donor screening
Age threshold: 65% blastocyst formation rate for donors ≤25 years old, 30% higher than 30 years old group
Biomarkers:
✅ AMH >3.5 ng/ml (adequate ovarian reserve)
✅ FSH <7 IU/L (efficient follicular recruitment)
✅ Mitochondrial DNA copy number >200k/ oocyte (optimization of energy metabolism)
Genetic exclusion: mandatory screening for SMN1 (spinal muscular atrophy), FMR1 (Fragile X Syndrome) and 98 other genetic disorders
(ii) “Soil improvement project” of the uterine environment
Structural repair:
→ hysteroscopic excision of adhesions (50% increase in implantation area)
→ ultrasound ablation of leiomyomas (preservation of endothelial integrity)
Blood flow revolution:
Sildenafil regimen: 25mg vaginally/day, 35% reduction in uterine arterial PIs4
Stem cell technology: uterine instillation of autologous bone marrow stem cells, 1.2±0.3mm increase in endothelial thickness
Accommodation calibration:
● ERA assay to correct for graft window shift (error <4 hours)
● Progesterone receptor gene polymorphisms to guide luteal support
(iii) The “three-generation technology leap” in embryo screening
| Technology Generation | Detection range | Benefits over 43 years of age |
|---|---|---|
| PGT-A 1.0 | 5 pairs of chromosomes | Miscarriage rate ↓25% |
| PGT-A 2.0 | 24 pairs of chromosomes | Aneuploidy detection rate ↑40% |
| PGT-M 3.0 | Monogenic disease + CNV | Healthy Embryo Acquisition Rate Surpasses 52% |
Note: Whole genome sequencing has made possible the live birth of chimeric (5%-20%) embryos*.
(iv) “Pre-pregnancy cleanup” for metabolic diseases
Thyroid storm: 3-fold increased risk of miscarriage with TSH >2.5 μIU/mL – need eugenol titration to 1.0-2.0 μIU/mL4
Insulin resistance: Metformin + inositol combination treatment in those with fasting glucose >5.3 mmol/L ↑ 28% of implantation rate
Pre-thrombotic state: Antiphospholipid antibody-positive patients The live birth rate of antiphospholipid antibody-positive patients increased from 19% to 74% with low molecular heparin treatment.
(v) “Neuroendocrine remodeling” for stress management
Cortisol paradox: 45% reduction in uterine blood flow when serum cortisol >14 μg/dL
Intervention protocol:
→ Positive thinking meditation (20 min daily for 8 weeks) → 120% increase in β-endorphin
→ Sleep optimization (fall asleep before 22:00) → melatonin synchronization of embryonic biological clocks
Clinical benefit: Harvard study confirms that psychosocial interventions increase live-birth rate of 43 year old women by 19%.
III. Science Against the Odds: A Practical Guide to Global Frontier Technologies
(i) “Embryo Banking” Accumulation Strategy
Applicable people: AMH <0.5 ng/ml or sinus follicles <3
Benefit analysis: 3 cycles of egg retrieval increased the rate of healthy embryos from 8% to 35% in 46-year-old women.
(ii) “Precise guidance” of the timing of implantation
Endothelial synchronization:
→ Estrogen initiation day setting (day 1-3 of menstruation)
→ Timing of progesterone conversion (ERA report calibration)
Embryo resuscitation technique:
Thawing and culturing to 24 hours after resuscitation for implantation (↑22% implantation rate)
Laser-assisted hatching (improvement of zona pellucida sclerosis)
(iii) Synergistic therapy “matrix of synergism”
| naturopathy | mechanism of action | Clinical Enhancement |
|---|---|---|
| hyperbaric medicine | Improvement of the hypoxic microenvironment of the uterus | Inner membrane thickness ↑0.8mm |
| give or have acupuncture and moxibustion | Regulation of prostaglandin PGE2 | Blood flow RI ↓ 0.15 |
| probiotic colonization | Reduction of the uterine inflammatory factor IL-6 | Embedding rate ↑18% |
Data source: European Society for Reproduction 2025 Guidelines for Integrative Medicine
Bioethics and future breakthroughs
(i) The “genetic rights” controversy in egg donation and in vitro fertilization
Paradox of anonymity: Spanish legislation requires information about egg donors to be stored for 20 years (traceable after offspring reach adulthood)
Epigenetic risk: stressful experiences of egg donors may affect fetal neurodevelopment via miRNAs – need to screen for depression history
(ii) Technology dawn in 2025
Artificial follicle technology: 3D bioprinted ovarian scaffolds rejuvenate granulosa cell function
Mitochondrial replacement: injecting egg donor cytoplasm into patient oocytes (clinical trial stage)
AI embryo prediction: time-lapse imaging system + deep learning, blastocyst screening with 93% accuracy
Conclusion: between science and hope
“Fertility decline is a biological law, but the desire to pass on life deserves the highest level of medical respect.” Johns Hopkins reproductive ethicist Dr. Lisa Chen’s declaration illustrates the true meaning of modern reproductive medicine.
40+ Women’s Action Checklist:
Mandatory tests: AMH + TSH + coagulation function (90 days prior to conception)
Egg donor matching: select egg donors ≤25 years old and with AMH >3.5 ng/ml
Uterine preparation: ERA test + 3D assessment of endothelial blood flow
Embryonic strategy: PGT-M 3.0 screening + phased cryotransplantation
Global resources:
→ Thailand: Jettynin Hospital 40+ Specialized Center (72% blastocyst formation rate)
→ USA: CCRM 53% live birth rate at advanced age
Ultimate formula: Successful live birth = (donor egg quality × uterine tolerance) ÷ Metabolic Disorder Index
When every variable is scientifically optimized, advanced age will eventually become a common footnote in the fertility journey.
相关推荐
- 5 Taboos After Embryo Transfer: International Reproductive Experts Guard Surrogate Mothers During Critical Period of Landing
- How does non-invasive technology select the “Chosen One” for IVF?
- Kyrgyzstan IVF Guide for Singles
- Breaking the invisible code of repeated IVF transfer failures
- NT / Down screening / non-invasive / amniocentesis full analysis
Search within the site
Surrogacy News
Hot Tags.
Kyrgyzstan Surrogacy Agency,Global IVF Hospitals,International Surrogate Mother Recruitment